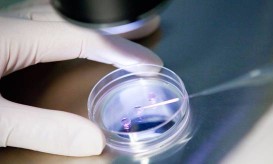

Ανδρέας Ξανθός: Το 2016 τα νοσοκομεία θα μπορούν να χορηγούν Φάρμακα Υψηλού Κόστους
Σύμφωνα με τον υπουργό Υγείας, οι αυξημένοι προϋπολογισμοί των νοσοκομείων για φέτος, θα επιτρέψουν την διάθεση των Φαρμάκων Υψηλού...

Σύμφωνα με τον υπουργό Υγείας, οι αυξημένοι προϋπολογισμοί των νοσοκομείων για φέτος, θα επιτρέψουν την διάθεση των Φαρμάκων Υψηλού...

Στην Επιτροπή Κοινωνικών Υποθέσεων της Βουλής των Ελλήνων μίλησε ο γ' αντιπρόεδρος του Πανελληνίου Φαρμακευτικού Συλλόγου, Γιάννης Δαγρές, απόντος...

"Φάρμακα στο σπίτι" ονομάζεται η νέα υπηρεσία των Ελληνικών Ταχυδρομείων, η οποία θα λειτουργεί σε συνεργασία με τον ΕΟΠΥΥ...

Περιορισμούς στη συνταγόγραφηση των φαρμάκων υψηλού κόστους καθώς και επέκταση των θεραπευτικών πρωτοκόλλων σε ακόμη 10 παθήσεις, ενεργοποιεί το...

Στην προκήρυξη πρόχειρου μειοδοτικού διαγωνισμού για την ανάθεση του έργου παροχής υπηρεσιών ταχυμεταφοράς φαρμάκων υψηλού κόστους από φαρμακεία του...

Η αποκλειστική διάθεση των Φαρμάκων Υψηλού Κόστους (ΦΥΚ) από τα φαρμακεία του ΕΟΠΥΥ και τα νοσοκομειακά φαρμακεία ήταν ένα...

Ανησυχία προκάλεσε στους ρευματοπαθείς η πληροφορία για διάθεση των φαρμάκων υψηλού κόστους για σοβαρές παθήσεις (φάρμακα του Ν3816) αποκλειστικά...

Παραγωγή φαρμάκων στην Ελλάδα, ιατρικός τουρισμός, σταθερό πλαίσιο φορολόγησης των πολυεθνικών αλλά και μέτρα για τους ανασφάλιστους και τους...

"Ανάσα" φέρεται να πήραν οι άνθρωποι της φαρμακοβιομηχανίας καθώς η συνάντηση με τον υπουργό Υγείας ξεκαθάρισε το τοπίο σε...

Στοιχεία της Ομοσπονδίας Συνεταιρισμών Φαρμακοποιών Ελλάδος (ΟΣΦΕ) που αφορούν στην κατανάλωση φαρμάκων και στην εξέλιξη στις τιμές στα φάρμακα...
Από ειδικές επιτροπές του ΕΟΠΥΥ θα περνούν τα ζευγάρια που επιθυμούν να υποβληθούν σε εξωσωματική γονιμοποίηση. Μέσω αυτών θα...

Κοντά στα 150 εκατ. ευρώ θα κληθούν να πληρώσουν οι φαρμακευτικές επιχειρήσεις με τη μορφή του clawback (επιστροφή χρημάτων...

Μόνο από τα νοσοκομεία και τα φαρμακεία του ΕΟΠΥΥ φαίνεται ότι θα μπορούν να παίρνουν τα φάρμακά τους οι...

Φάρμακα σοβαρών ασθενειών μόνο για ...λίγους φαίνεται ότι προωθεί ο ΕΟΠΥΥ. Την ώρα που εκδίδει διευκρινιστική εγκύκλιο για το...

Δραματικές είναι οι στιγμές που ζουν εκατοντάδες συνάνθρωποί μας που πάσχουν από σοβαρά νοσήματα και πλέον δεν μπορούν να...